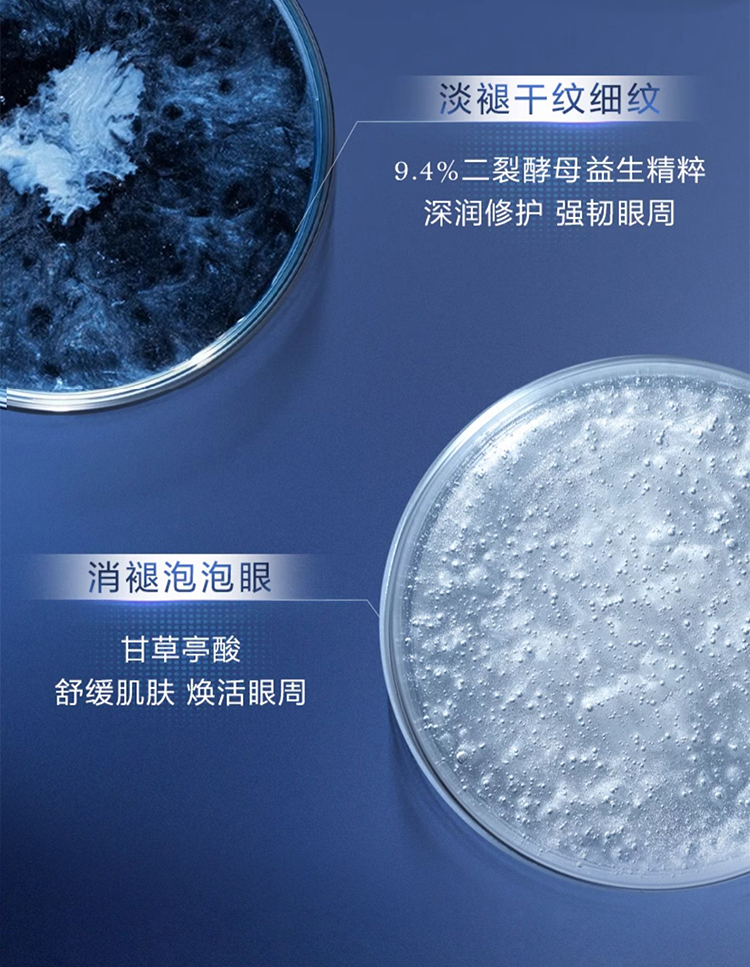

兰蔻新款超修两件礼盒款 (小黑瓶肌底液100ml新款+小黑瓶眼霜20ml 新款 ) 带礼盒礼品袋 送礼优享
¥898.00
限时折扣
原价:¥2980.00
| 运费: | ¥ 0.00-20.00 |
| 库存: | 17 件 |
商品详情

- 全球购 (微信公众号认证)
- 扫描二维码,访问我们的微信店铺
- 随时随地的购物、客服咨询、查询订单和物流...